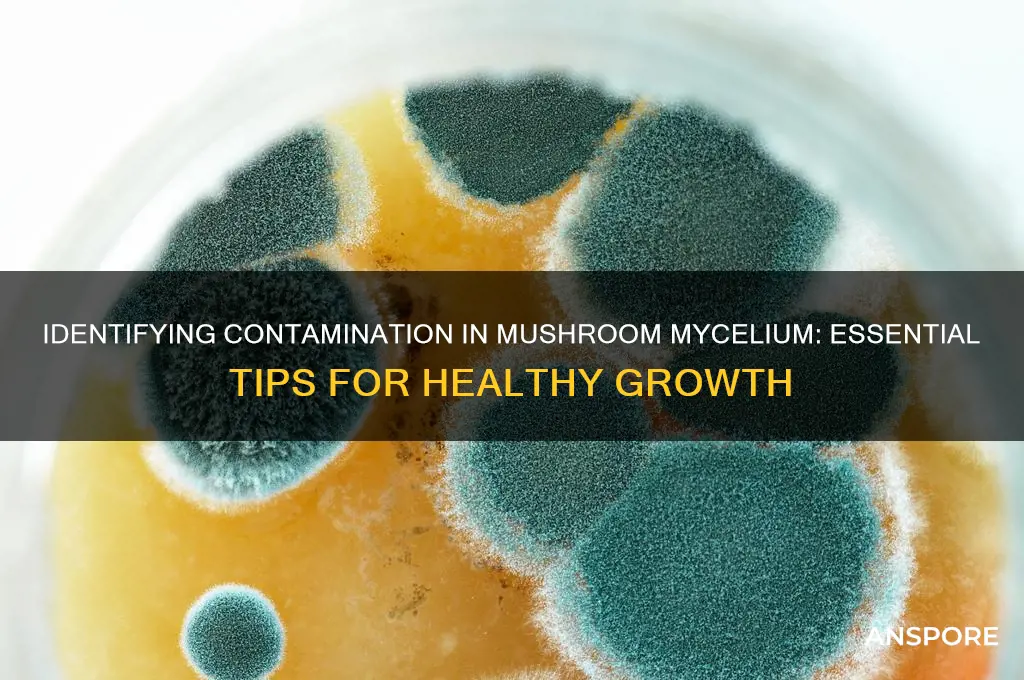
how to spot contamination i mushroom mycelium

Spotting contamination in mushroom mycelium is crucial for successful cultivation, as contaminants like mold, bacteria, or competing fungi can quickly compromise the entire grow. Early detection involves closely monitoring the substrate and mycelium for unusual colors, textures, or odors; healthy mycelium typically appears white, fluffy, and uniform, while contamination may manifest as green, black, or yellow patches, slimy textures, or a foul smell. Regularly inspecting the growing environment for foreign spores, maintaining sterile practices, and using clear containers for better visibility are essential preventive measures. Identifying contamination promptly allows for immediate intervention, such as isolating the affected area or discarding the contaminated batch, to protect the rest of the cultivation process.
Explore related products
What You'll Learn
- Visual Signs: Look for discoloration, unusual growth patterns, or mold on the mycelium surface
- Odor Changes: Detect foul, sour, or ammonia-like smells indicating bacterial contamination
- Texture Alterations: Identify slimy, mushy, or dry patches instead of healthy, fluffy mycelium
- Pest Presence: Spot insects, mites, or larvae feeding on or near the mycelium
- Contaminant Types: Recognize common invaders like Trichoderma, cobweb mold, or bacteria colonies

Visual Signs: Look for discoloration, unusual growth patterns, or mold on the mycelium surface
When inspecting mushroom mycelium for contamination, visual signs are your first line of defense. Healthy mycelium typically appears as a dense, white, fluffy network, often described as "arachnoid" or cobweb-like. Any discoloration should immediately raise a red flag. Contaminants like bacteria or mold can cause the mycelium to turn yellow, brown, green, or even black. For instance, a greenish tint might indicate the presence of Trichoderma, a common fungal contaminant, while black spots could suggest bacterial growth. Always compare the current color to the initial healthy white appearance to spot deviations early.
Another critical visual cue is unusual growth patterns. Healthy mycelium grows uniformly, spreading outward in a consistent, even manner. If you notice areas where the mycelium appears watery, slimy, or clumped together, this could indicate contamination. Contaminants often disrupt the natural growth pattern, causing the mycelium to look patchy or uneven. For example, bacterial contamination might cause the mycelium to appear wet or glossy, while mold contamination can lead to localized dense, fuzzy patches that differ from the normal texture.
Mold on the mycelium surface is a clear and alarming visual sign of contamination. Mold often appears as distinct colonies with colors ranging from green, blue-green, or black. Unlike healthy mycelium, mold tends to grow in circular patterns or as a fuzzy layer on the surface. It’s important to note that not all molds are easily visible in the early stages, so regular, close inspection is crucial. If you spot any mold-like growth, it’s essential to act quickly to isolate the contaminated area to prevent further spread.
In addition to discoloration and mold, pay attention to texture changes. Healthy mycelium is typically dry and fluffy, whereas contaminated mycelium may feel damp, slimy, or gritty. For instance, bacterial contamination often results in a wet, sticky texture, while mold can make the surface feel fuzzy or powdery. These textural changes, combined with visual abnormalities, provide a more comprehensive assessment of potential contamination.
Lastly, localized abnormalities are key indicators of contamination. While the majority of the mycelium may appear healthy, contamination often starts in small, localized areas. Look for spots where the mycelium seems to be dying back, turning darker, or becoming discolored. These areas are breeding grounds for contaminants and should be monitored closely. If left unchecked, contamination can spread rapidly, compromising the entire culture. Regular, thorough inspection of the mycelium surface is essential to catch these early warning signs.
Sautéing Mushrooms: Quick, Easy, and Delicious
You may want to see also

Odor Changes: Detect foul, sour, or ammonia-like smells indicating bacterial contamination
One of the most reliable ways to detect bacterial contamination in mushroom mycelium is by paying close attention to odor changes. Healthy mycelium typically has a mild, earthy, or slightly fungal scent. However, if you notice foul, sour, or ammonia-like smells, it is a strong indicator of bacterial contamination. These odors arise because bacteria produce byproducts like organic acids or ammonia as they break down the substrate. When you open a container or bag containing mycelium, take a moment to inhale carefully. If the smell is unpleasant or sharply deviates from the usual earthy aroma, it’s time to investigate further.
Sour smells are particularly indicative of lactic acid bacteria, which thrive in moist, nutrient-rich environments like mushroom substrates. These bacteria ferment sugars in the substrate, producing lactic acid and a distinct sour odor. If left unchecked, this contamination can quickly spread, outcompeting the mycelium for resources. Similarly, ammonia-like smells suggest the presence of bacteria that break down proteins into ammonia, a toxic compound that can inhibit mycelium growth. Both of these odors are red flags and require immediate action to prevent further contamination.
To detect these odor changes effectively, regularly inspect your mycelium during the colonization phase. Use transparent containers or small viewing windows to minimize disturbance while checking. If you’re working with bulk substrates, gently lift a small portion to sniff without exposing the entire batch to potential contaminants. Keep in mind that odor detection is subjective, so compare the smell to known healthy mycelium if possible. If you’re unsure, err on the side of caution and assume contamination if the odor is off.
Addressing odor-related contamination promptly is crucial. Once detected, isolate the contaminated container to prevent the spread of bacteria to other cultures. Dispose of the contaminated substrate and mycelium in a sealed bag to avoid cross-contamination. Sterilize all tools and surfaces that came into contact with the contaminated material. For future prevention, ensure proper sterilization of substrates and maintain a clean workspace. Additionally, monitor environmental conditions like humidity and temperature, as imbalances can create favorable conditions for bacterial growth.
In summary, odor changes are a critical early warning sign of bacterial contamination in mushroom mycelium. Foul, sour, or ammonia-like smells indicate the presence of harmful bacteria that can jeopardize your entire cultivation effort. By regularly inspecting your mycelium and taking immediate action at the first sign of unusual odors, you can protect your cultures and maintain a healthy growing environment. Always prioritize cleanliness and proper sterilization to minimize the risk of contamination in the first place.
White Mushrooms: Are They a Good Source of Fiber?
You may want to see also

Texture Alterations: Identify slimy, mushy, or dry patches instead of healthy, fluffy mycelium
When inspecting your mushroom mycelium for contamination, one of the most critical aspects to observe is the texture. Healthy mycelium typically appears as a fluffy, cotton-like growth that is uniform in texture. However, any deviations from this healthy appearance can be a red flag. Texture alterations such as slimy, mushy, or dry patches are common indicators of contamination. These changes often signify the presence of unwanted bacteria, molds, or other microorganisms that thrive in the same conditions as your mycelium. Early detection of these texture abnormalities is crucial to saving your mushroom cultivation project.
Slimy patches are a particularly concerning sign of contamination. Healthy mycelium should never feel wet or slippery to the touch. If you notice a glossy, gelatinous layer on the surface or within the substrate, it’s likely caused by bacterial growth. This slime is often a byproduct of bacteria breaking down organic matter, which can quickly spread and outcompete your mycelium for resources. To identify slimy contamination, gently press a sterile tool or gloved finger onto the surface—if it leaves a wet, sticky residue, immediate action is necessary to isolate and address the issue.
Mushy or waterlogged areas are another texture alteration to watch for. While mycelium naturally retains some moisture, overly soggy or mushy patches indicate poor drainage or the presence of water-loving contaminants like certain molds or yeasts. These areas may appear darker or discolored compared to the healthy, fluffy mycelium. Mushiness can also result from overwatering or improper substrate preparation, creating an environment conducive to contamination. Regularly check the moisture levels and ensure proper ventilation to prevent such issues.
On the opposite end of the spectrum, dry patches can also signal trouble. Healthy mycelium thrives in a consistently moist environment, so dry, brittle areas suggest either dehydration or the presence of contaminants that disrupt water absorption. Dry patches may appear lighter in color and lack the vibrant, alive texture of healthy mycelium. This could be caused by competing organisms that deplete moisture or by environmental factors like excessive airflow. Monitoring humidity levels and maintaining a balanced growing environment are essential to prevent dryness and its associated risks.
To effectively identify texture alterations, regular visual and tactile inspections are key. Use a magnifying glass if needed to spot subtle changes, and always work in a sterile environment to avoid introducing new contaminants. If you detect slimy, mushy, or dry patches, isolate the affected area immediately to prevent further spread. Proper documentation of your observations can also help track patterns and improve future cultivation practices. By staying vigilant and addressing texture alterations promptly, you can protect your mycelium and ensure a successful mushroom harvest.
Mushroom Magic: Nature's Antidepressant?
You may want to see also
Explore related products

Pest Presence: Spot insects, mites, or larvae feeding on or near the mycelium
Pest presence is a critical indicator of contamination in mushroom mycelium, as insects, mites, and larvae can quickly damage or destroy your crop. These pests are attracted to the nutrient-rich environment that mycelium provides, making early detection essential for maintaining a healthy grow. To spot pest infestations, start by regularly inspecting your growing area with a magnifying glass or a bright light. Look for tiny movements or clusters of small organisms on the surface of the mycelium or in the surrounding substrate. Common pests include fungus gnats, sciarid flies, and spider mites, which may appear as dark specks or webs near the mycelium.
Insects and larvae often leave visible signs of their presence, such as chewed or discolored mycelium, frass (insect waste), or small holes in the substrate. For example, fungus gnat larvae feed on the mycelium and roots, causing stunted growth or wilting. Adult gnats may be seen hovering around the growing area. Mites, though microscopic, can be detected by the fine webbing they produce or the stippling and yellowing of the mycelium they cause. Regularly examining the edges and underside of the mycelium mat can reveal these early warning signs before the infestation spreads.
Larvae, in particular, can be devastating as they burrow into the substrate and consume the mycelium from within. To check for larvae, gently probe the substrate with a sterile tool or your gloved finger, looking for movement or small white or translucent worms. If you notice any unusual activity or damage, isolate the affected area immediately to prevent the pests from spreading to other parts of your grow. Implementing preventive measures, such as using fine mesh screens and maintaining proper hygiene, can also reduce the risk of pest infestations.
Monitoring humidity and temperature levels is another effective way to deter pests, as many thrive in overly damp or warm conditions. Keep your growing environment clean and free of organic debris, as this can attract pests. If you suspect a pest problem, introduce natural predators like predatory mites or nematodes to control the infestation without harming the mycelium. Chemical pesticides should be a last resort, as they can disrupt the delicate balance of your grow ecosystem.
Finally, documenting your observations through photos or notes can help track the progression of a pest infestation and determine the effectiveness of your control measures. Early intervention is key to managing pests and preserving the health of your mushroom mycelium. By staying vigilant and proactive, you can minimize the impact of pests and ensure a successful harvest. Regular inspections and a clean growing environment are your best tools in the fight against contamination from insects, mites, and larvae.
Mushroom Spawn Types: Do They Make a Difference?
You may want to see also

Contaminant Types: Recognize common invaders like Trichoderma, cobweb mold, or bacteria colonies
When cultivating mushroom mycelium, recognizing contamination early is crucial to saving your crop. Among the most common invaders are Trichoderma, cobweb mold, and bacteria colonies, each with distinct characteristics that set them apart from healthy mycelium. Trichoderma is a fast-spreading fungus that often appears as green or white patches with a fuzzy texture. Unlike the uniform growth of mushroom mycelium, Trichoderma tends to grow in localized, rapidly expanding spots, sometimes with a greenish hue that becomes more pronounced over time. It thrives in similar conditions as mushroom mycelium, making it a persistent threat. If left unchecked, it can quickly overtake your substrate, producing spores that further contaminate the environment.
Cobweb mold is another frequent contaminant, characterized by its white, fluffy, and web-like appearance, resembling a spider’s web. This mold grows rapidly and can cover large areas of the substrate, often starting as small, cotton-like patches that expand into a dense mat. Cobweb mold is particularly problematic because it competes with mushroom mycelium for nutrients and space, stifling its growth. Unlike healthy mycelium, which appears thread-like and consistent, cobweb mold lacks structure and feels dry and brittle to the touch. Early detection is key, as it can spread quickly, especially in humid conditions.
Bacteria colonies present differently from fungal contaminants, often appearing as discolored, slimy, or wet patches on the substrate. These colonies can range in color from yellow and brown to black, depending on the bacterial species. Unlike the dry, fibrous texture of mycelium, bacterial contamination feels moist and may emit a foul odor, indicating decay. Bacteria thrive in environments with excess moisture, so poor drainage or overwatering can exacerbate this issue. While bacteria may not always be visible in the early stages, their presence often becomes apparent as they disrupt the mycelium’s growth, causing it to appear patchy or discolored.
Each of these contaminants requires specific management strategies. Trichoderma is difficult to eradicate once established, so prevention through sterile techniques and careful monitoring is essential. Cobweb mold can sometimes be controlled by improving air circulation and reducing humidity, but heavily contaminated substrates may need to be discarded. Bacterial colonies often indicate underlying issues like excessive moisture or poor substrate preparation, which must be addressed to prevent recurrence. Regular inspection of your growing environment and familiarity with these contaminants’ appearances will help you act swiftly to protect your mushroom mycelium.
In summary, recognizing Trichoderma, cobweb mold, and bacteria colonies involves observing their unique textures, colors, and growth patterns. Trichoderma’s green or white fuzzy patches, cobweb mold’s white web-like structure, and bacteria’s slimy, discolored colonies all stand in stark contrast to the healthy, uniform growth of mushroom mycelium. Early detection and understanding of these contaminants’ behaviors are vital for maintaining a successful mushroom cultivation process. By staying vigilant and addressing issues promptly, you can minimize the risk of contamination and ensure the health of your mycelium.
Mushroom Mystery: Yeast or Not?
You may want to see also
Frequently asked questions
Contamination often appears as discoloration (green, black, or brown patches), fuzzy or powdery growths, or unusual textures (slimy or dry spots) that differ from the healthy white or light-colored mycelium.
Bacterial contamination may cause a foul odor, slimy texture, or rapid discoloration, often accompanied by a wet or mushy appearance in the substrate.
Yes, mold contamination typically appears as colorful (green, blue, or black) fuzzy growths, while healthy mycelium is usually uniform in color and texture without fuzziness.
Trichoderma contamination is characterized by rapid green growth that spreads quickly, often overtaking the mycelium, and may produce a musty smell.











































